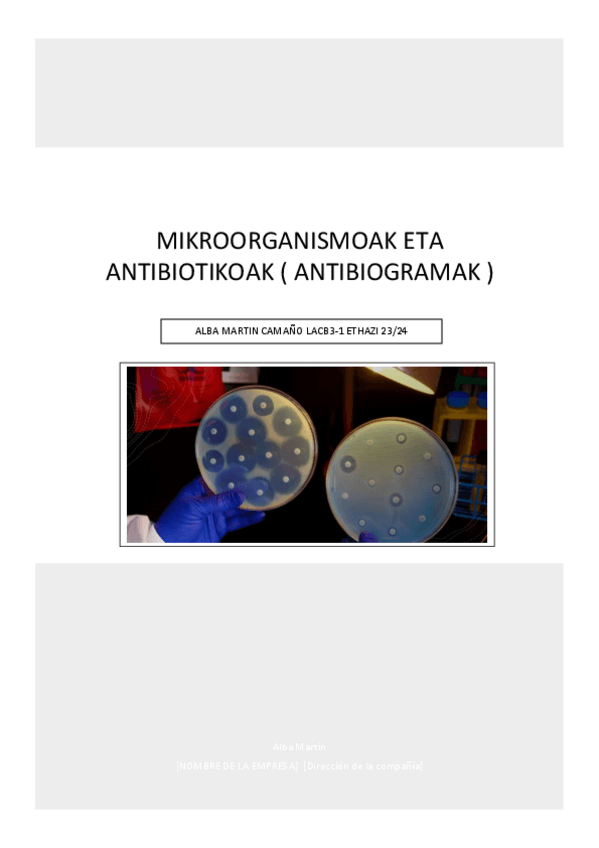

@camanoalba
Bio: Laboratorista Clínica & Biomédica | Estudiante de Psicología, aspirante a médico Psiquiatra. Actualmente estudio Psicología porque creo firmemente que entender la mente es tan importante como comprender el cuerpo.
66 Publicaciones
750 Interacciones
133 Seguidores
4 Siguiendo
Lista de publicaciones de camanoalba
TEST REPASO PSICOLOGÍA
¡Hola a todos! Mediante esta publicación os enseño una nueva serie de test de repaso diseñados específicamente para preparar los exámenes de Psicología. 🧠 Los he preparado con mucho detalle para ayudar a repasar los conceptos clave y evaluar qué temas llevamos mejor. Podéis encontrarlos en el enlace señalado. ¡Espero que os sirvan de ayuda ! Mucho ánimo con el estudio.
Os dejo por aquí unos tips rápidos para estudiar el croquis de Neuro y no morir en el intento. - Subrayad por bloques: Para T1 y T2 (método/ética), para T3 (genética) y para los temas del cerebro (T4 al T10). Ayuda muchísimo a la memoria visual. - Las
Resumen compacto con puntos clave , para preparación de examen.
Psicología de la Personalidad y Diferencias Individuales I: Tema 1 / Primer Cuatrimestre. Set de apuntes esquemáticos para repasar antes de un examen o una clase. Todo el contenido está resumido en formato de esquemas y tablas para memorizar lo esencial e
¡Apuntes del primer cuatrimestre de Desarrollo Psicomotor, Cognitivo y Lingüístico listos!
Ya he subido mis apuntes de Desarrollo Psicomotor, Cognitivo y Lingüístico Están organizados por temas e incluyen resúmenes, tablas... y ejemplos clave para repasar fácilmente. Si te sirve para estudiar o repasar, ¡échales un vistazo y cuéntame qué te parecen! #Psicología #UNIR #DesarrolloPsicomotor #ApuntesUNIR #EstudioEnComunidad

apuntes
-
Desarrollo Psicomotor, Cognitivo y Lingüístico
Apuntes y Esquematización completa : Desarrollo (Temas 1 al 10) Primer Cuatrimestre Incluye : - Fundamentos Teóricos - Fundamentos Metodológicos de Investigación en Psicología del Desarrollo - Evaluación y Valoración de los Trastornos del Desarrollo Psi
Alba Martín Camaño – UNIR, Grado en Psicología Este trabajo expone la relación entre la neurociencia y el coaching, destacando cómo los avances en el conocimiento del cerebro respaldan la efectividad de las prácticas de coaching en el desarrollo del auto
apuntes
-
Hematología
Apuntes sobre morfología celular sanguínea, hematopoyesis, parámetros hematimétricos, y alteraciones frecuentes. Incluye técnicas diagnósticas como frotis periférico, recuento diferencial, y pruebas de coagulación.
apuntes
-
Biología Molecular y Citogenética
Apuntes sobre estructura y función de ácidos nucleicos, enzimas asociadas y técnicas de hibridación molecular
apuntes
-
Técnicas de Inmunodiagnóstico
He publicado nuevos apuntes de Técnicas de inmunodiagnóstico: Técnicas de Inmunodiagnóstico
apuntes
-
Microbiología Clínica / Mikrobiologia Klinikoa
He publicado nuevos apuntes de Microbiología Clínica: Microbiología Clínica / Mikrobiologia Klinikoa
apuntes
-
Fisiopatología General
Fisiopatología General
apuntes
-
Gestión de Muestras Biológicas/Lagin Biologikoen kudeaketa
He publicado nuevos apuntes de Análisis Bioquímico: Gestión de Muestras Biológicas/Lagin Biologikoen kudeaketa